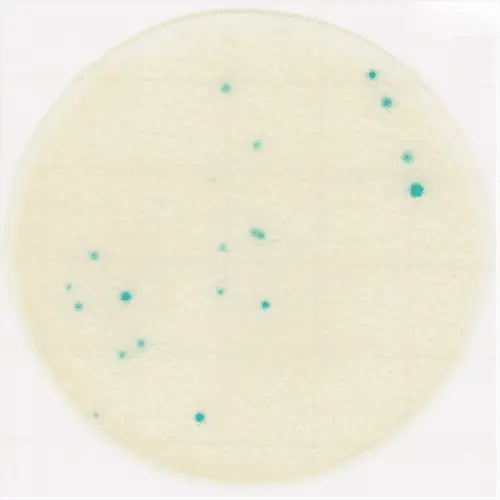
KIKKOMAN 61981 Easy Plate CC

KIKKOMAN 61981 Easy Plate CC Instruction Manual
CAUTION !
CAUTION !
- Do not attempt to eat this product, touch the growth area with bare hands or allow the medium to get into eyes.
- Please make sure to read the precautions and instructions in this Instruction Manual before attempting to use the device and exercise extreme caution when using it.
Easy Plate CC is a microbiological culture device made up of a waterproof sheet, a readymade dry medium on the sheet and a transparent cover over the medium. The Easy Plate CC method is intended to indicate the level of coliform bacteria in food products as an alternative to the Violet Red Bile Agar method in U.S. Food and Drug Administration’s Bacteriological Analytical Manual (FDA-BAM): Enumeration of Escherichia coli and the Coliform Bacteria. It is compact and easy to use, and reduces the total amount of waste produced during testing. The Easy Plate CC method has been granted AOAC Research Institute Performance Tested MethodsSM (021401) for raw ground pork, raw lamp, raw ground chichken, raw tuna fillet, raw salmon fillet, raw shrimp, fresh peeled banana, fresh cut pineapple, and fresh cut apples.
Procedure
Sample preparation
- Weigh each 50 g test portion into a blender jar.
- Add 450 mL Butterfield’s phosphate-buffered diluent (BPD) and blend for up to 2 minutes. For a recipe of BPD, see the FDA website (BAM Reagents R11).
- Prepare all decimal dilutions with 90 mL BPD plus 10 mL previous dilution.
- Shake 25 times in a 30 cm arc.
Inoculation
- Remove each Easy Plate CC sheet from an aluminum bag under aseptic conditions.
- Place the sheet on a flat surface and allow it to reach room temperature (15-25℃).
- Lift the cover and place 1 mL sample suspension onto the center of the medium.
- Drop the cover onto the sample.
Do not use the sheet with a bent cover to ensure the sample spreads on the entire medium. - Leave the sheet for 3 minutes or more on a horizontal surface.
Do not move or tilt the sheet until solidification of the suspension is completed to avoid the sample being spilled out from the growth area. - Hold both ends of the sheet and carry it into an incubator.
The sheets can be held after the solidification without any time restriction.
Incubation
Incubate the sheets at 35 ± 1℃ for 24 ±1 hours. It is possible to stack up to 25 sheets.
Interpretation
Count all blue colonies regardless of size or intensity. The suitable colony counting range is 1-250.
Troubleshooting for counting colonies:
a) When a number of colonies per sheet exceeds 250, for all dilutions, record the count as too numerous to count (TNTC). If an estimated count is required, count colonies within 1-3 squares (1 cm x 1 cm) printed on the cover and calculate an average. Multiplying the average number by 20 provides the estimated count since the circular growth area is approximately 20 cm2.
b) When the entire growth area becomes blue, record the count as too numerous to count (TNTC).
c) When a bubble disrupts a colony so that the colony outlines the bubble, count it as one colony.
d) When a colony is spreading, count it as one colony.
e) When two or more spreading colonies appear to originate from separate sources, count each source as one colony.
f) When the sample is not clear (i.e. cloudy or dark), prepare a higher dilution.
g) When the entire growth area become blue due to food components involving the chromogenic reaction, prepare a higher dilution.
h) When colonies are extremely small or light, incubate continuously for a few hours to make the colony size larger or the colony color intensity darker
Precautions
- This product is not for clinical testing.
- This product has not been tested with all possible food products, food processes, test protocols or strains.
- Do not open the cover until just before inoculation.
- Do not use the product after its expiry date.
- Do not use the product that is damaged, deformed or discolored, or that contains any foreign materials.
- Do not expose the product to direct sunlight.
- Do not push the cover after inoculation to avoid sample suspension being spilled out from a growth area.
- If sample suspension spilled out from a growth area, try again with a new sheet.
- If medium or reagent gets into eyes or mouth, rinse immediately with plenty of water and consult a doctor.
- Analysis needs to be performed under a laboratory analyst with microbiological training and supervision. All waste must be handled as a biohazard and disposed by autoclaving.
Storage
Keep in the refrigerator (2-8℃).
The product can be stored below 25°C for up to 14 days or below 30°C for up to 5 days before opening an aluminum bag. Storage at 25°C and 30°C have not been validated under AOAC Research Institute PTM 021401.
Storage after opening the bag
Put any unused sheet back into the bag, fold the end of the bag over twice, and seal with tape. The shelf life under refrigerated condition is 3 months after opening.
Shelf life
Expiry date is specified on the product label after the word “EXP”. The shelf life of the product is 18 months after manufacturing if it is stored properly without opening the bag.
Disposal
Any and all media, supplements, and reagents must be sterilized by autoclaving after use, and then disposed as industrial waste according to local laws and regulations.
Warranty
Kikkoman Biochemifa Company warrants the products to have a certain level of quality. This warranty guarantees that Kikkoman Biochemifa Company shall replace defective products should any be found. This warranty does not provide any other guarantees. Kikkoman Biochemifa Company shall not be liable for any damages, including special or consequential damages, or expenses arising directly or indirectly from the use of this product.
Kikoman Biochemifa Company
2-1-1, Nishi-shinbashi, Minato-ku, Tokyo 105-0003, Japan
Tel: +81 3 5521 5178
E-mail: [email protected]
URL: https://biochemifa.kikkoman.co.jp/e/
© 2021 Kikkoman Corp. (20210701)




















